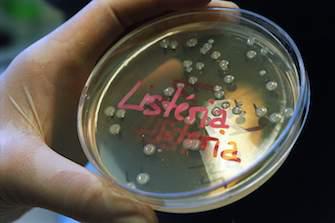

L’Agence européenne de la sécurité alimentaire (EFSA) tire la sonnette d’alarme. Depuis 5 ans, le nombre de listérioses en Europe progresse sans interruption, signale son dernier rapport. Cette maladie d’origine alimentaire peut être très grave puisqu’elle infecte le sang. Les experts sont d’autant plus inquiets que les souches incriminées sont plus invasives et résistantes.
Moins de salmonellose
La campylobactériose, principalement transmise par la volaille, reste la maladie d’origine alimentaire la plus répandue en Europe. Elle continue de reculer, tout comme la salmonellose (- 8 %), un succès salué par l’EFSA. « Mais nous ne devons pas baisser notre garde car d’autres maladies, comme la listériose ou les infections par VTEC (E. coli qui produit de la vérocytoxine, ndlr) sont en hausse », souligne Marta Hugas, Directrice du département d’évaluation des risques à l’EFSA.
La progression des infections par VTEC n’inquiète pas l’EFSA outre mesure. En effet, l’Agence attribue en grande partie cette hausse à la vigilance accrue des Etats membres après la flambée épidémique de 2011.
Des infections graves
Entre 2012 et 2013, la listériose a progressé de 8,6 %. Le nombre de cas reste relativement faible – 1 763 en 2013 – mais ils inquiètent les experts. En effet, la majorité des patients présentent des formes invasives et graves de cette maladie qui infecte le sang, et parfois le système nerveux. C’est d’ailleurs la maladie d’origine alimentaire la plus mortelle. Les immunodéprimés et les personnes âgées sont particulièrement à risque.
« Les infections proviennent le plus souvent d’aliments prêts à consommer », s’alarme Mike Catchpole, Directeur scientifique au Centre européen de contrôle et de prévention des maladies (ECDC). La situation est d’autant plus critique que la Listeria monocytogenes, souche à l’origine de la maladie chez l’Homme, est rarement détectée au-dessus du seuil de sécurité dans les aliments prêts à consommer. Les symptômes, eux, sont relativement classiques. La plupart du temps, les malades souffrent d'un syndrome grippal.